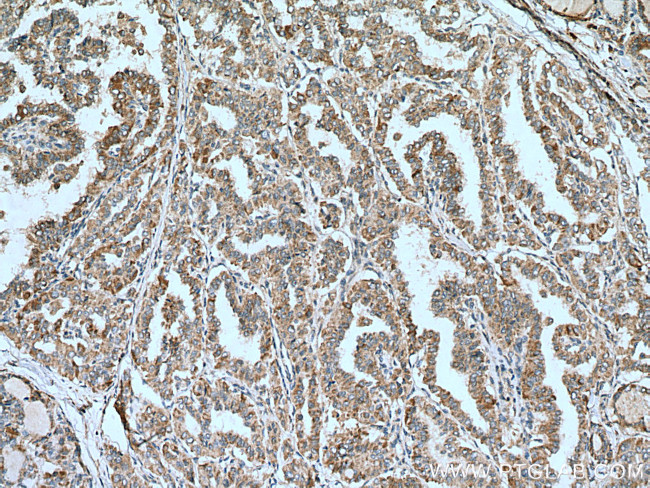
ALG3 Antibody in Immunohistochemistry (Paraffin) (IHC (P))

Search
Proteintech
ALG3 Polyclonal Antibody
{{$productOrderCtrl.translations['antibody.pdp.commerceCard.promotion.promotions']}}
{{$productOrderCtrl.translations['antibody.pdp.commerceCard.promotion.viewpromo']}}
{{$productOrderCtrl.translations['antibody.pdp.commerceCard.promotion.promocode']}}: {{promo.promoCode}} {{promo.promoTitle}} {{promo.promoDescription}}. {{$productOrderCtrl.translations['antibody.pdp.commerceCard.promotion.learnmore']}}
产品信息
20290-1-AP
种属反应
宿主/亚型
分类
类型
抗原
偶联物
形式
浓度
规格
纯化类型
保存液
内含物
保存条件
运输条件
产品详细信息
Aliquoting is unnecessary for -20°C storage.
靶标信息
This gene encodes a member of the ALG3 family. The encoded protein catalyzes the addition of the first dol-P-Man derived mannose in an alpha 1,3 linkage to Man5GlcNAc2-PP-Dol. Defects in this gene have been associated with congenital disorder of glycosylation type Id (CDG-Id) characterized by abnormal N-glycosylation. Multiple transcript variants encoding different isoforms have been found for this gene.
仅用于科研。不用于诊断过程。未经明确授权不得转售。
生物信息学
蛋白别名: asparagine-linked glycosylation 3 homolog (S. cerevisiae, alpha-1,3-mannosyltransferase); asparagine-linked glycosylation 3 homolog (yeast, alpha-1,3-mannosyltransferase); asparagine-linked glycosylation 3, alpha-1,3- mannosyltransferase homolog; Asparagine-linked glycosylation protein 3 homolog; carbohydrate deficient glycoprotein syndrome type IV; Dol-P-Man-dependent alpha(1-3)-mannosyltransferase; Dol-P-Man:Man(5)GlcNAc(2)-PP-Dol alpha-1,3-mannosyltransferase; dol-P-Man:Man(5)GlcNAc(2)-PP-Dol3-mannosyltransferase; Dolichyl-P-Man:Man(5)GlcNAc(2)-PP-dolichyl mannosyltransferase; Dolichyl-phosphate-mannose--glycolipid alpha-mannosyltransferase; Not56-like protein; unnamed protein product
基因别名: ALG3; CDG1D; CDGS4; CDGS6; D16Ertd36e; NOT; Not56; NOT56L
UniProt ID: (Human) Q92685
Entrez Gene ID: (Human) 10195